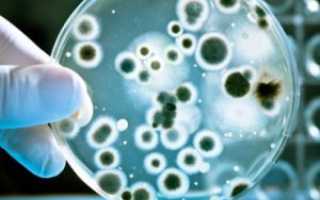

Амебиаз — инфекционное заболевание, вызываемое простейшими рода Entamoeba, главным образом Entamoeba histolytica. Оно может проявляться от легких расстройств пищеварения до тяжелых форм колита и абсцессов. Знание признаков амебиаза, методов диагностики и лечения поможет своевременно обратиться за медицинской помощью и избежать осложнений. Эта статья объясняет, что такое амебиаз, как его распознать и какие меры предпринять для эффективного лечения.
Возбудитель и причины амебиаза
Почему возникает амебиаз и что это за заболевание? Среди паразитарных инфекций амебиаз занимает второе место по уровню смертности среди взрослых, уступая лишь малярии. Эта болезнь широко распространена в тропических регионах, особенно в местах с низким уровнем санитарии. Именно поэтому ее относят к заболеваниям, связанным с «грязными руками».
Возбудителем амебиаза является дизентерийная амеба — одноклеточный паразит. Она существует в двух формах: вегетативной и цистной (покойной). Заражение, как правило, происходит именно в форме цисты.
Передача паразита осуществляется исключительно от человека: от носителя цист (при бессимптомном течении) или от пациента с хронической формой амебиаза в период ремиссии. В случае острого течения или обострения хронической формы из организма выделяются не цисты, а активные амебы, которые быстро погибают вне человеческого тела.
Существует три основных пути передачи амебиаза: через пищу, воду и контактный способ. Наиболее часто цисты попадают в организм с пищей и питьевой водой. При контактном способе заражение происходит через загрязненные руки, что может привести к инфицированию предметов быта и продуктов. В редких случаях цисты могут передаваться при анальном сексе.
Цисты сохраняют жизнеспособность в окружающей среде до 2-4 недель.
Заражение происходит, когда циста попадает в кишечник, где начинается инкубационный период, продолжающийся несколько недель. Если иммунная система человека сильная, заболевание может протекать бессимптомно. Затем цисты превращаются в вегетативную форму и проникают в кишечные ткани, вызывая кишечный амебиаз. Если цисты проникают в ткани других органов, развивается внекишечный амебиаз.
Переход амебы из покоя в активную форму ускоряется под воздействием жаркого климата, дисбактериоза, глистных инвазий, недостатка белка в рационе, беременности и ослабления иммунной системы.
Амебиаз — это инфекционное заболевание, вызванное простейшими микроорганизмами рода Entamoeba. Врачи выделяют основные симптомы амебиаза: диарею, боли в животе и возможные признаки интоксикации, такие как высокая температура и слабость. Следует отметить, что у некоторых пациентов заболевание может протекать без явных симптомов, что затрудняет его диагностику.
Лечение амебиаза, по мнению специалистов, должно быть комплексным и включать антипротозойные препараты, такие как метронидазол или тинидазол, а также поддерживающую терапию. Врачи также акцентируют внимание на профилактике, поскольку инфекция передается через загрязненные продукты и воду. Соблюдение правил личной гигиены и санитарных норм значительно снижает риск заражения. В целом, ранняя диагностика и адекватное лечение играют ключевую роль в успешном выздоровлении пациентов.
Амебиаз является инфекционным заболеванием, вызванным простейшими микроорганизмами рода Entamoeba. Эксперты отмечают, что основными симптомами амебиаза являются диарея, боли в животе и, в некоторых случаях, лихорадка. Заболевание может проявляться как остро, так и хронически, что затрудняет его диагностику. Важно отметить, что амебиаз может привести к серьезным осложнениям, таким как абсцесс печени, если не начать своевременное лечение.
Лечение обычно включает применение антипротозойных препаратов, таких как метронидазол или тинидазол, которые эффективно уничтожают паразитов. Врачи подчеркивают важность ранней диагностики и обращения к специалисту при появлении первых симптомов. Профилактика включает соблюдение правил личной гигиены и осторожность при употреблении пищи и воды в регионах с высоким риском заражения.

Симптомы амебиаза
После того как взрослый человек заразился амебиазом, он некоторое время (от недели до нескольких месяцев) никаких симптомов болезни не заметит. Затем постепенно начнут возникать постоянные или нарастающие схваткообразные боли в желудке, сопровождающиеся:
- вздутием живота;
- частым жидким стулом, в котором заметна примесь слизи и крови;
- ложными позывами на дефекацию;
- тошнотой и рвотой;
- лихорадкой;
- понижением работоспособности;
- слабостью;
- учащенным сердцебиением;
- снижением артериального давления.
Через 1-1,5 месяца эти симптомы амебиаза исчезают и наступает период ремиссии: болезнь переходит в хроническую форму. Но по происшествии нескольких недель или месяцев заболевание снова начинает обостряться.
Хроническая форма амебиаза обнаруживается:
- неприятным вкусом во рту;
- белым налетом на языке;
- втянутым болезненным животом;
- отсутствием аппетита;
- похудением;
- образованием абсцессов, кист, амебом и полипов.
Иногда может встречаться декомпенсация органов, которая чаще всего выражается в виде тахикардии и увеличении размеров печени.
У маленьких детей и у людей с ослабленным иммунитетом амебиаз может развиться мгновенно (на протяжении первых двух суток). У больных появляются сильные боли, диарея, лихорадка, интоксикация и обезвоживание организма. На кишечной стенке образовываются язвы, развивается парез и перитонит. Часто наблюдается летальный исход.
Признаки внекишечного амебиаза:
- при печеночном амебиазе увеличивается и уплотняется печень, поднимается температура, иногда наблюдается развитие желтухи;
- при амебной пневмонии в легких появляются абсцессы, гнойный плеврит, боль в области груди, одышка, лихорадка, кашель с отхаркиванием мокрот, которые содержат кровь и гной;
- при мочеполовом амебиазе воспаляются мочевыводящие пути и половые органы;
- при амебном менингоэнцефалите в головном мозге развиваются абсцессы, и больной часто умирает еще до установления диагноза.
Симптомы кожного амебиаза проявляются в виде язв и эрозий на коже, имеющих неприятный запах. В основном поражаются ягодицы, промежность, область вокруг заднепроходного отверстия.
| Симптом | Тяжесть | Лечение |
|---|---|---|
| Бессимптомное носительство | Легкая | Наблюдение, возможно профилактическое лечение |
| Диарея (водянистая, слизистая, кровянистая) | Легкая-тяжелая | Метронидазол, тинидазол, орнидазол |
| Боли в животе | Легкая-тяжелая | Спазмолитики, противовоспалительные препараты |
| Тошнота, рвота | Легкая-средняя | Противорвотные препараты, регидратация |
| Лихорадка | Легкая-тяжелая | Жаропонижающие препараты |
| Дегидратация | Тяжелая | Регидратация (внутривенно или перорально) |
| Амебная дизентерия | Тяжелая | Метронидазол, тинидазол, орнидазол, возможно хирургическое вмешательство |
| Амебный абсцесс печени | Тяжелая | Метронидазол, возможно хирургическое вмешательство, дренирование абсцесса |
| Амебные поражения других органов | Тяжелая | Зависит от локализации, часто требуется хирургическое вмешательство и специфическая противоамебная терапия |
Интересные факты
Вот несколько интересных фактов об амебиазе:
-
Причинитель заболевания: Амебиаз вызывается простейшим организмом Entamoeba histolytica. Этот микроорганизм может вызывать как бессимптомное носительство, так и тяжелые формы заболевания, включая амебную дизентерию, которая проявляется сильной диареей с кровью и слизью.
-
Способы передачи: Амебиаз передается фекально-оральным путем, что означает, что инфекция может распространяться через загрязненную воду или пищу. Это делает амебиаз особенно распространенным в регионах с низким уровнем санитарии и гигиены.
-
Лечение: Лечение амебиаза обычно включает применение антипротозойных препаратов, таких как метронидазол или тинидазол. Важно также проводить лечение для устранения носительства, чтобы предотвратить повторное заражение и распространение инфекции.

Лечение амебиаза
Амебиаз может быть вылечен за несколько дней, однако в некоторых случаях боли и диарея могут сохраняться на протяжении нескольких недель. Рецидивы заболевания также не редкость. При легком течении болезни возможно амбулаторное лечение, в то время как при тяжелой форме потребуется госпитализация.
Для терапии амебиаза используются различные группы медикаментов:
- Лекарства с прямым контактным действием (например, хиниофон, дийодохин) назначаются при хроническом амебиазе в стадии ремиссии;
- Препараты для лечения острого кишечного и внекишечного амебиаза (эметин, дигидроэмитин, амбильгар, хинамин, делагил);
- Средства с универсальным действием (метронидазол, фурамид), которые подходят для всех форм амебиаза;
- Антибиотики, влияющие на микробный баланс в кишечнике;
- Ферментные препараты, помогающие при колитическом синдроме (дигестал, панзинорм);
- Лекарства для восстановления нормальной микрофлоры кишечника (пребиотики, пробиотики, симбиотики).
В дополнение к медикаментозному лечению рекомендуется придерживаться белковой диеты и витаминной терапии. При кожном амебиазе лечение медикаментами сочетается с использованием мазей на основе ятрен.
Если амебиаз сопровождается анемией, пациентам назначаются препараты с содержанием железа и комплексные витамины. При тяжелом течении болезни могут быть проведены внутривенные инъекции реополиглюкина.
Для удаления абсцессов может потребоваться хирургическое вмешательство.
Амебиаз — это инфекционное заболевание, вызванное простейшими микроорганизмами рода Entamoeba. Люди, сталкивающиеся с этой болезнью, часто описывают симптомы как крайне неприятные. К основным проявлениям относятся диарея, боли в животе, а также возможные лихорадка и слабость. В некоторых случаях инфекция может протекать бессимптомно, что затрудняет диагностику. Лечение амебиаза обычно включает применение антипротозойных препаратов, таких как метронидазол или тинидазол. Важно также поддерживать водный баланс и следить за питанием. Профилактика заключается в соблюдении гигиенических норм и употреблении чистой воды, особенно в регионах с низким уровнем санитарии. Люди, столкнувшиеся с этой проблемой, подчеркивают важность своевременного обращения к врачу для предотвращения осложнений.
Профилактика
Чтобы предотвратить заражение амебиазом, прежде всего, необходимо соблюдать правила гигиены. Людям, проживающим в эпидемиологически неблагополучных регионах, рекомендуется периодически проводить химиопрофилактику. Для этой цели используют хиниофон и метронидазол.
Помещение, в котором находится больной дезинфицируют, применяя 3%-й раствор лизола или 2%-й раствор крезола. Люди, излечившиеся от амебиаза, на протяжении года находятся под диспансерным наблюдением.
Лица, входящие в группу риска, каждый год сдают анализы на наличие цист амебы. В группу риска относят:
- людей, страдающих хроническими кишечными инфекциями;
- туристов, приехавших из тропических стран;
- продавцов продуктовых товаров;
- работников пищевых предприятий;
- людей, работающих с канализационными и очистными сооружениями;
- рабочих парников и теплиц;
- гомосексуалистов.
Также обследование на содержание цист проходят люди, которые собираются работать в детских учреждениях, на пищевых предприятиях, в санаториях, на водоочистных сооружениях. Санэпидемстанция осуществляет строгий контроль состояния источников водоснабжения и канализаций.

Что будет, если не лечить амебиаз?
Если не проводить лечение амебиаза у взрослых, то периоды ремиссии и обострения могут длиться на протяжении многих лет. Заболевание может вызвать как кишечные, так и внекишечные осложнения.
При кишечных осложнениях могут возникать:
- периколит и перитонит;
- перфорация стенки кишечника;
- кишечное кровотечение;
- сужение просвета кишки;
- амебный аппендицит;
- расслаивающийся колит;
- гангрена слизистой оболочки;
- выпадение кишечника;
- кишечная непроходимость;
- образование полипов, кист и амеб.
Что касается внекишечных осложнений, то они могут привести к нарушениям гормонального обмена, а также к проявлениям анемии, гиповитаминоза, обезвоживания и истощения. Если не устранить эти осложнения, это может закончиться летальным исходом для пациента.
Что такое амебиаз простыми словами?
Амебиаз или амебная дизентерия – это инфекционное заболевание, вызываемое простейшим и передающееся от человека к человеку. Широко распространен в тропических и субтропических регионах – Азии, Африке, Латинской Америке. В России эндемичными районами являются Закавказье, Краснодарский край и юг Приморья.
Где можно заразиться амебой?
Амебиаз является распространенным заболеванием, особенно в странах с субтропическим и тропическим климатом. Эта инфекция представляет собой серьезную проблему в Африке, а также в большинстве стран Азии, Южной и Центральной Америки. Плохие санитарные условия и низкий уровень жизни в этих регионах способствуют распространению инфекции.
Как понять, что в тебе амеба?
Симптомы первичного амебного менингоэнцефалита начинаются в течение 1–2 недель. Иногда первыми симптомами являются изменения вкуса или запаха. Позже у людей появляется головная боль, тугоподвижность шеи, повышенная чувствительность к свету, тошнота и рвота.
Какой паразит вызывает амебиаз?
Амебиаз вызывается амебой Entamoeba histolytica, чей жизненный цикл состоит из двух фаз: активной вегетативной (трофозоит) и стадии покоя (циста).
Диагностика амебиаза
Диагностика амебиаза включает в себя несколько ключевых этапов, направленных на подтверждение наличия инфекции, вызванной амебами, в организме пациента. Основные методы диагностики включают:
- Клинический осмотр: Врач проводит тщательный опрос пациента о симптомах, таких как диарея, боли в животе, лихорадка и другие проявления. Важно выяснить, были ли у пациента поездки в эндемичные регионы, где амебиаз распространен.
- Лабораторные исследования: Основным методом диагностики является анализ кала. В лаборатории исследуют образцы кала на наличие цист или трофозоитов амеб. Для более точной диагностики может потребоваться несколько образцов, так как выделение паразитов может быть непостоянным.
- Серологические тесты: В некоторых случаях применяются серологические тесты для выявления антител к амебам в крови. Эти тесты могут быть полезны, если анализ кала не дал однозначных результатов.
- Инструментальные методы: В сложных случаях, когда есть подозрение на осложнения, такие как абсцесс печени, может потребоваться ультразвуковое исследование или компьютерная томография. Эти методы позволяют визуализировать внутренние органы и выявить возможные поражения.
Важно отметить, что диагностика амебиаза должна проводиться квалифицированным медицинским специалистом, так как симптомы могут перекрываться с другими заболеваниями, такими как бактериальная диарея или язвенный колит. Правильная диагностика и своевременное лечение играют ключевую роль в предотвращении осложнений и улучшении состояния пациента.
Вопрос-ответ
Чем опасна амеба для человека?
Амеба, поедающая мозг, — это тип амебы, которая обычно прячется в теплых пресноводных водоемах или грязных, неочищенных водах. Когда она попадает в организм человека, она вызывает смертельную инфекцию и воспаление в мозге, что в конечном итоге приводит к «разъеданию» мозговой ткани.
Какая группа антибиотиков применяется при кишечной форме амебиаза?
Для лечения кишечного амёбиаза и внекишечных форм в настоящее время применяют преимущественно метронидазол или тинидазол.
Советы
СОВЕТ №1
Обратите внимание на симптомы. Амебиаз может проявляться различными признаками, такими как диарея, боли в животе и лихорадка. Если вы заметили у себя или у близких подобные симптомы, не откладывайте визит к врачу для диагностики и назначения лечения.
СОВЕТ №2
Соблюдайте правила гигиены. Чтобы предотвратить заражение амебами, старайтесь мыть руки перед едой и после посещения туалета. Также избегайте употребления неочищенной воды и сырых продуктов в регионах с высоким риском амебиаза.
СОВЕТ №3
Следите за своим питанием. При лечении амебиаза важно поддерживать сбалансированное питание, чтобы укрепить иммунную систему. Включайте в рацион больше фруктов, овощей и белков, чтобы помочь организму справиться с инфекцией.
СОВЕТ №4
Не занимайтесь самолечением. Если у вас диагностирован амебиаз, строго следуйте рекомендациям врача и не прерывайте курс лечения, даже если симптомы исчезли. Это поможет избежать рецидивов и осложнений.